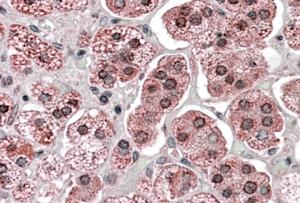

> Antigen, Antibodies, ELISA, Western Blot > Primary Antibody > Polyclonal Antibodies > Goat Anti-KPNA6 AntibodyBrand |
Leading Biology | Catalog Number |
APR16319G |
Product Type |
Polyclonal Antibodies | Field of Research |
|
Product Overview |
We constantly strive to ensure we provide our customers with the best antibodies. As a result of this work we offer this antibody in purified format.
We are in the process of updating our datasheets. If you have any questions regarding this update, please feel free to contact our technical support team.
This product is a high quality Goat Anti-KPNA6 antibody.
|
||
Molecular Weight |
60030 Da
|
||
Host |
Goat
|
||
Species Reactivity |
Human
|
||
Isotype |
IgG
|
||
Symbol |
IPOA7
|
||
GeneID |
|||
UniProt ID |
|||
Function |
Functions in nuclear protein import as an adapter protein for nuclear receptor KPNB1. Binds specifically and directly to substrates containing either a simple or bipartite NLS motif. Docking of the importin/substrate complex to the nuclear pore complex (NPC) is mediated by KPNB1 through binding to nucleoporin FxFG repeats and the complex is subsequently translocated through the pore by an energy requiring, Ran- dependent mechanism. At the nucleoplasmic side of the NPC, Ran binds to importin-beta and the three components separate and importin-alpha and -beta are re-exported from the nucleus to the cytoplasm where GTP hydrolysis releases Ran from importin. The directionality of nuclear import is thought to be conferred by an asymmetric distribution of the GTP- and GDP-bound forms of Ran between the cytoplasm and nucleus.
|
||
Summary |
Nucleocytoplasmic transport, a signal- and energy-dependent process, takes place through nuclear pore complexes embedded in the nuclear envelope. The import of proteins containing a nuclear localization signal (NLS) requires the NLS import receptor, a heterodimer of importin alpha and beta subunits also known as karyopherins. Importin alpha binds the NLS-containing cargo in the cytoplasm and importin beta docks the complex at the cytoplasmic side of the nuclear pore complex. In the presence of nucleoside triphosphates and the small GTP binding protein Ran, the complex moves into the nuclear pore complex and the importin subunits dissociate. Importin alpha enters the nucleoplasm with its passenger protein and importin beta remains at the pore. The protein encoded by this gene is a member of the importin alpha family.
|
||
Form |
0.5 mg IgG/ml in Tris saline (20mM Tris pH7.3, 150mM NaCl), 0.02% sodium azide, with 0.5% bovine serum albumin |
||
Storage & Stability |
Store at +4°C short term. For long-term storage, aliquot and store at -20°C or below. Stable for 12 months at -20°C. Avoid repeated freeze-thaw cycles.
|
||
Applications |
WB, IHC, E
|
||
Synonyms |
Importin subunit alpha-7, Karyopherin subunit alpha-6, KPNA6, IPOA7
|
||
Images |

APR16319G (0.1 μg/ml) staining of Human Muscle lysate (35 μg protein in RIPA buffer). Primary incubation was 1 hour. Detected by chemiluminescence.
APR16319G (3.8 μg/ml) staining of paraffin embedded Human Adrenal Gland. Steamed antigen retrieval with citrate buffer pH 6, AP-staining. |
||
Specification |
|||
Quantity |
|
||
| Select | Brand | Catalog No. | Product Name | Pack Size | Type | Field of Research | Specification | Quantity | Price(USD) | |
| 1 | Leading Biology | APR03440G | ITGA11 Antibody (N-term) | 100 μl | Polyclonal Antibodies |
|
$495.00 | Add Ask | ||
| 2 | Leading Biology | APR04537G | CMIP Antibody (C-term) | 100 μl | Polyclonal Antibodies |
|
$495.00 | Add Ask | ||
| 3 | Leading Biology | APR12422G | Human H4 Histamine Receptor (extracellular) Antibody | 50 μl | Polyclonal Antibodies |
|
$695.00 | Add Ask | ||
| 4 | Leading Biology | APR03844G | UBE2W Antibody (C-term) | 100 μl | Polyclonal Antibodies |
|
$495.00 | Add Ask | ||
| 5 | Leading Biology | APR04349G | HECTD2 Antibody (N-term) | 100 μl | Polyclonal Antibodies |
|
$495.00 | Add Ask | ||
| 6 | Leading Biology | APR03502G | IGHG1 Antibody (Center) | 100 μl | Polyclonal Antibodies |
|
$495.00 | Add Ask |
 Leading Biology Inc.
2600 Hilltop DR, Building G, B Suite C138
Richmond, CA, 94806
Tel: 1-661-524(LBI)-0262
Email: info@leadingbiology.com
Leading Biology Inc.
2600 Hilltop DR, Building G, B Suite C138
Richmond, CA, 94806
Tel: 1-661-524(LBI)-0262
Email: info@leadingbiology.com
Complete this form and click send to ask us a question, request a quote or simply say hello.

You have 0 item in your cart

You have 0 item in your inquiry list
